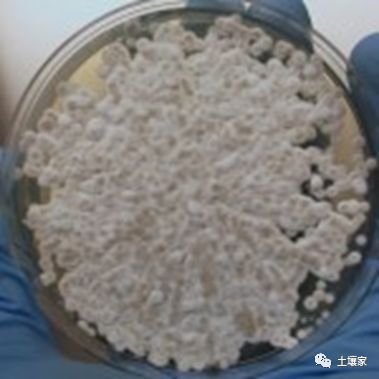
研究人员用香蕉的防霉菌--玫瑰红球菌治疗蝙蝠的白鼻症

导 读
据研究报道蝙蝠是冠状病毒的自然宿主,因此我们有必要多多了解一下这只丑八怪的生态圈!
生物之间相生相克,蝙蝠本身也也生病。这篇文章从能防止香蕉发霉的细菌中发现可以治愈感染小棕蝙蝠的白鼻综合症方法。认为将动物短暂暴露于某些细菌喷出的气体中似乎可以治愈感染。特翻译出来,或者能给出一些参考。翻译水平有限,敬请谅解 。
编译/陈能场(广东省生态环境技术研究所研究员、中国科协环境生态领域首席传播专家)
原题:Biowarfare saves bats from killer fungus
网址:https://www.sciencenewsforstudents.org/article/biowarfare-saves-bats-killer-fungus
作者:史蒂芬·奥恩斯(Stephen Ornes)
时间:2015年6月8日




(治疗)成功了的(蝙蝠)脸。这款小棕蝙蝠已被成功治疗了白鼻综合症,之后于2015年5月投放野外。美国森林服务局
寻求治愈白鼻综合症(美国蝙蝠的主要杀手)的研究人员刚刚报告了巨大的成功。一种新的治疗方法挽救了被感染蝙蝠的生命。它为他们的野生亲属带来了一线希望。引起白鼻综合症的真菌已经威胁到一些种群的灭绝。
5月19日,这种潜在的治疗方法的有效性可见一斑。当夜幕降临时,科学家们聚集在密苏里州汉尼堡(Hannibal)的洞穴附近。那天晚上,他们把150只经过处理过的蝙蝠放归野外。去年秋天,这些蝙蝠都患有白鼻综合症。
在过去的十年中,这种感染夺走了美国和加拿大超过570万只蝙蝠的生命。但是在周二,研究人员宣布被治疗的动物足够健康,可以返回他们称之为家的洞穴中。在短时间内,蝙蝠一只只飞进了昏暗的夜空。
科学家们探索了许多治疗白鼻综合症的方法,但是那天晚上标志着治疗过的蝙蝠第一次回到野外。在加拿大温尼伯大学(University of Winnipeg)学习蝙蝠的生物学家克雷格·威利斯(Craig Willis)说,他对这项成功感到鼓舞。同时,“我们需要进一步了解[蝙蝠和治疗方法],然后才能将其称为‘治愈’”未参与该项目的威利斯说。

在这个洞穴中,包裹着冬眠的小棕色蝙蝠的蜘蛛网状纤维垫是导致白鼻综合征的真菌。这是一种特别极端的感染。有时,真菌似乎只是蝙蝠鼻子上撒上糖粉。美国鱼类和野生动物管理局Moriarty Marvin
白鼻综合症以在蝙蝠的鼻子和翅膀上生长的白色霉菌命名,是由Pseudogymnoascus destructans(也被称为Pd,SU-doh-JIM-no-ASK-usDIH-STRUK-tans)引起的。这种真菌不会杀死欧洲的蝙蝠,在那里它似乎已经进化了。真菌也不会使受感染的动物患上流感。相反,它吃他们的翅膀上的洞,削弱他们的力量。最终,受感染的蝙蝠变得太虚弱,无法捕食。
保护生物学家西比尔·阿梅隆(Sybill Amelon)在美国密苏里州哥伦比亚市的美国森林服务局工作。她在开发新疗法方面发挥了重要作用。该疗法依赖于一种叫做玫瑰红球菌(Rhodococcus rhodochrous)(ro-doh-KOK-kusROH-doh-krus)的细菌。尽管Amelon对该疗法的早期成功感到兴奋,但她告诫说,最近的试验仅涉及少数蝙蝠。此外,她指出,更重要的是,这种治疗方法只能治愈约一半的被感染动物。
Amelon和她的团队保留了一些复原的蝙蝠,并计划在下一个冬天对其进行观察,以确保它们保持健康。现在知道新疗法将持续多久还为时过早。
尽管如此,挽救一群受感染的蝙蝠仍然是一个重要的里程碑:它们可以返回洞穴重新建立垂死的种群。这种新疗法可能只是生物学家为遏制白鼻综合症的致命影响而转向的众多工具之一。
向香蕉学习
灵感可能来自不太可能的地方。 Christopher Cornelison是亚特兰大乔治亚州立大学的生物学家。他一直对野生动植物充满热情。当他还是一名研究生时,他第一次听说真菌病把数千只蝙蝠抹灭了。他是研究玫瑰红球菌的团队的一员。这些研究人员一直在研究这些细菌如何分解土壤中的化学物质。
但是研究小组的科学家注意到这种细菌具有非同寻常的特性。它防止香蕉发霉。而且细菌甚至不必接触香蕉或霉菌。细菌释放到空气中的气体阻止了霉菌的生长,霉菌是一种真菌。储存室内没有这些细菌的香蕉确实会发霉。
Cornelison回忆说,突然我脑海中闪过了一个念头。 “也许,如果这种细菌可以阻止霉菌在香蕉上生长,它可以防止霉菌在蝙蝠身上生长。”
进一步的测试将证实他是对的。 2012年,Amelson的一位林业局同事在密苏里州将科内利森的一些数据发送给了她。这样,合作就诞生了。除了Cornelison和Amelon,他们的团队现在还包括Daniel Lindner。他是威斯康星州麦迪逊市的森林服务真菌学家或真菌专家。
Lindner说:“我对真菌和蘑菇以及它们所能做的一切着迷, 与此同时,当它们不合时宜时,可能会导致毁灭性疾病。”像白鼻综合症。
这是造成白鼻综合症的真菌-Pseudogymnoascus destructans。乔治亚州立大学的KyleGabriel和Robert Simmons。
从实验室到现场
两年来,Amelon,Cornelison和Lindner组成了一个团队,该团队运行实验室测试,优化调整细菌治疗方案。去年秋天,在密苏里州的两个地点和肯塔基州的两个地点,科学家们去了蝙蝠开始冬眠的洞穴。他们在那里收集了被感染的动物。他们将每只蝙蝠放入一个足够大的冷却器中,以容纳约100罐苏打水。该冷却器还装有一个生长细菌的小器皿。 24至48小时后,科学家将每只蝙蝠取下,并放在他们在其居家洞穴中创造的保护用的围栏中(栅栏用来防止了捕食者)。
今年春天,科学家们回来了。约有一半被感染的蝙蝠不再显示出任何感染迹象。这些幸存者是最近释放的蝙蝠。(科学家们尚未将其研究结果发表在科学期刊上,因此他们将不会报告治疗了多少只蝙蝠以及存活了多少只蝙蝠的确切数字。)
尽管试验看起来很有希望,但在治疗可用于洞穴和其他冬眠之前,仍有许多问题需要回答——蝙蝠在冬季冬眠的地方。
人们最关心的是这些地点的其他生命。越冬巢具有令人眼花乱的各种微生物,真菌、动物和其他生物。所有生命以微妙的平衡生活在一起。将玫瑰红球菌添加进来可能会破坏这种平衡。
例如,肯尼斯·菲尔德(Kenneth Field)指出:“有成千上万种其他真菌生活在洞穴中,它们可能也可能不会受到细菌的影响。”宾夕法尼亚州刘易斯堡的巴克内尔大学的这位生物学家没有参与这项研究。他告诉《学生科学新闻》(Science News for Students),一个担忧是,在(生命)混合体系中添加一些新细菌可能会危害整个生态系统。

欢迎来到蝙蝠洞。研究人员在田纳西州克拉克斯维尔附近建造了这个地下室,用于冬眠蝙蝠。他们的目标是帮助蝙蝠免受可能生活在洞穴中的杀手真菌的侵害。蝙蝠的入口在顶部看起来像个烟囱。人们进入这里可能会以为一些地下寺庙。史蒂芬·奥恩斯(Science News for Students)
但是,如果科学家能够证明添加治疗性细菌不会对洞穴原生微生物造成大的风险,那么“我们可以应用它”,Cornelison说。他建议从“人工洞穴”开始。这些通常是人为建造的结构,蝙蝠可以安全地冬眠,如同矿井或战时用来护体的地堡。他们还包括专门为蝙蝠建造的地下建筑。在夏季,可以对这些结构进行消毒,以消除蝙蝠在前一个冬天带来的任何Pd真菌。田纳西州的一个这样的人造洞穴成功地吸引了蝙蝠进入冬眠。
即使细菌证明是安全的,治疗冬眠蝙蝠也将带来一些挑战。制造足够的细菌来治疗整个冬眠需要大量的工作和金钱。因此研究人员将必须找到一种低成本的方法来繁殖细菌。
尽管如此,观看最初一波复原的蝙蝠飞入汉尼堡的夜空还是第一步,这是非常有希望的一步。
